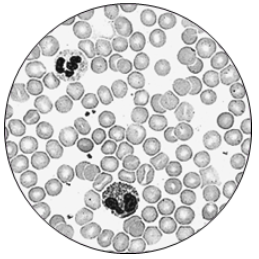

- Биология
- Авторские пробники от NeoFamily
- Бумажный сборник NeoFamily (ЕГЭ-2025). Вариант №10
Бумажный сборник NeoFamily (ЕГЭ-2025). Вариант №10
Рассмотрите таблицу "Уровни организации живого" и заполните ячейку, вписав соответствующий термин.
|
Уровень организации живого |
Иллюстрация уровня |
|
Тканевый |
|
|
? |
|
Экспериментатор внес в пробирку с пшеничной мукой 2 мл слюны человека. Как спустя 15 минут в пробирке изменилось содержание крахмала и аминокислот? Для каждой величины определите соответствующий характер ее изменения:
1) увеличится
2) уменьшится
3) не изменится
Запишите выбранные цифры для каждой величины. Цифры в ответе могут повторяться.
| Содержание крахмала | Содержание аминокислот |
В клетке корня хвоща полевого содержится 216 хромосом. Определите количество хромосом в клетках заростка хвоща. В ответ запишите только соответствующее число.
Какое количество генотипов образуется при самоопылении растения, являющегося потомком от скрещивания гомозиготных организмов с разными (альтернативными) признаками? Ответ запишите в виде числа.

Каким номером на схеме показана структура клетки, участвующая в образовании субъединиц рибосом?
Установите соответствие между характеристиками и структурами, обозначенными на рисунке цифрами 1, 2, 3: к каждой позиции, данной в первом столбце, подберите соответствующую позицию из второго столбца.

|
ХАРАКТЕРИСТИКА |
СТРУКТУРА |
|
А) является полуавтономным органоидом |
1) 1 |
|
Б) выполняет секреторную функцию |
2) 2 |
|
В) место синтеза стероидных гормонов |
3) 3 |
|
Г) обеспечивает синтез фосфолипидов | |
|
Д) обеспечивает окисление пирувата |
|
|
Е) место формирования первичных лизосом |
Запишите выбранные цифры под соответствующими буквами.
Выберите три верных ответа из шести и запишите цифры, под которыми они указаны. Для бластулы ланцетника характерны следующие признаки:
1) включает эктодерму и энтодерму
2) состоит из бластомеров
3) следующая стадия после морулы
4) содержит комплекс осевых органов
5) представляет собой однослойный зародыш
6) имеет отверстие - бластопор
Установите последовательность этапов репродукции ретровируса. Запишите соответствующую последовательность цифр.
1) сборка новых вирусных частиц
2) проникновение вирусного генома в клетку
3) встраивание вирусной ДНК в геном клетки
4) синтез вирусных белков
5) синтез вирусной ДНК в ходе обратной транскрипции

Каким номером на рисунке отмечен паразитический организм, обитающий в кишечнике человека?
Установите соответствие между характеристиками и организмами, обозначенными на рисунке выше цифрами 1, 2, 3: к каждой позиции, данной в первом столбце, подберите соответствующую позицию из второго столбца.

| ХАРАКТЕРИСТИКА | ОРГАНИЗМ |
| А) имеет смешанный тип питания | 1) 1 |
| Б) обладает положительным фототаксисом | 2) 2 |
| В) удаляет непереваренные остатки через порошицу | 3) 3 |
| Г) отсутствует пелликула | |
| Д) половой процесс осуществляется в форме конъюгации | |
| Е) перемещается с помощью псевдоподий |
Запишите выбранные цифры под соответствующими буквами.
Выберите три верных ответа из шести и запишите цифры, под которыми они указаны. Для аскариды человеческой характерны следующие особенности:
1) формирование вторичной полости тела
2) созревание яйца в аэробной среде
3) миграция личинок по дыхательным путям хозяина
4) всасывание питательных веществ поверхностью тела
5) анаэробность всех личиночных стадий
6) половой диморфизм взрослых особей
Установите последовательность систематических групп, начиная с самого низкого ранга. Запишите соответствующую последовательность цифр.
1) Грибы
2) Сморчковые
3) Сморчки
4) Эукариоты
5) Сморчок съедобный
6) Аскомицеты

Какой цифрой обозначен сосуд, несущий в малом круге кровообращения венозную кровь?
Установите соответствие между характеристиками и внутренними средами организма, обозначенными на рисунке выше цифрами 1, 2, 3: к каждой позиции, данной в первом столбце, подберите соответствующую позицию из второго столбца.

| ХАРАКТЕРИСТИКА | ВНУТРЕННЯЯ СРЕДА |
| А) обеспечивает отток избыточной жидкости из тканей | 1) 1 |
| Б) содержит все типы форменных элементов | 2) 2 |
| В) образуется непосредственно из плазмы крови | 3) 3 |
| Г) содержит дыхательный пигмент | |
| Д) при скоплении между клетками вызывает отеки | |
| Е) циркулирует по слепо замкнутым капиллярам |
Запишите выбранные цифры под соответствующими буквами.
Выберите три верных ответа из шести и запишите цифры, под которыми они указаны. Витамин А в отличие от витамина D:
1) входит в состав зрительного пигмента
2) является жирорастворимым
3) синтезируется в коже человека
4) при гиповитаминозе приводит к куриной слепоте
5) образуется из каротина
6) содержится в печени морской рыбы